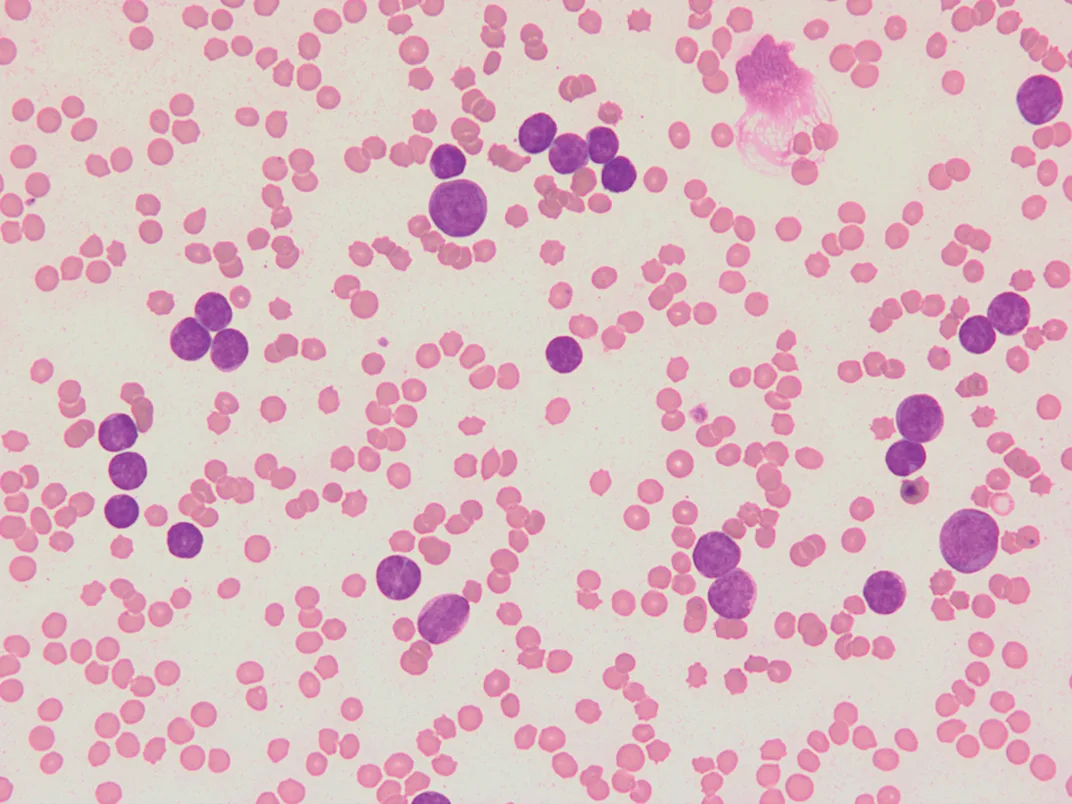
Featured Image

Feline Acute Lymphoblastic Leukemia
Timothy M. Fan, DVM, PhD, DACVIM (Oncology, Internal Medicine), University of Illinois at Urbana–Champaign

In the Literature
Tomiyasu H, Doi A, Chambers JK, et al. Clinical and clinicopathological characteristics of acute lymphoblastic leukaemia in six cats. J Small Anim Pract. 2018;59(12):742-746.
The Research …
Hematopoietic cancers (ie, liquid tumors) arise from malignantly transformed bone marrow precursor cells and include leukemia, lymphoma, and myeloma. Although lymphoma is well-defined in dogs and cats,1 the comparative rarity of leukemia and myeloma, particularly in cats,2-4 has created a barrier for elucidating the biologic and clinical behaviors of such cancers. Leukemias can be categorized by cell lineage (eg, lymphoid, myeloid) and biologic behavior (ie, acute, chronic).5-8 In companion animals, most leukemias are lymphoid in origin and can be subcategorized as B-cell or T-cell immunophenotype. In dogs, considerable advancements have been made toward improving the clinical diagnosis and management of lymphoid leukemias5; however, the clinical presentation of specific forms of lymphoid (ie, acute) leukemias in cats remains incompletely defined.
This retrospective case series described the clinical and clinicopathologic characteristics of acute lymphoblastic leukemia (ALL) in a small cohort of cats (n = 6) from a single institution over a 10-year period. Methodologically, diagnosis of ALL was reached using different molecular techniques, including PCR for antigen receptor gene rearrangements, flow cytometry, and/or immunohistochemistry. Clinically, cats diagnosed with ALL were presented most commonly for nonspecific signs, including anorexia, lethargy, diarrhea, weight loss, and/or vomiting. Peripheral lymphadenopathy was not clinically evident in any of the cats. The most frequent clinicopathologic abnormalities were thrombocytopenia and anemia, although directional abnormalities in leukocyte counts were not consistent among patients. The number of malignant lymphoblasts in circulation did not correlate with the degree of bone marrow infiltration with cancer cells. In aggregate, these observations derived from a small number of cats suggest that ALL can present heterogeneously in a population of cats and that, overall, prognosis is generally poor, regardless of therapeutic intervention. Additional prospective studies are necessary to gain a deeper understanding of the biology and management of ALL in cats.
Peripheral blood smear from a cat presented with clinical signs and marked leukocytosis identified on CBC. Neoplastic blasts predominate, with immunephenotyping revealing B-cell lymphoid leukemia. 50× magnification; photo courtesy of Dr. Anne Barger, University of Illinois at Urbana–Champaign
… The Takeaways
Key pearls to put into practice:
The absence of elevated circulating lymphoblasts does not exclude a diagnosis of ALL.
Diagnosis of ALL is best achieved through a combination of molecular techniques (eg, PCR for antigen receptor gene rearrangements, flow cytometry, immunohistochemistry).
The prognosis of ALL remains poor, regardless of instituted therapy, and retroviral infections with FeLV are often associated with ALL diagnosis in younger cats.
You are reading 2-Minute Takeaways, a research summary resource presented by Clinician’s Brief. Clinician’s Brief does not conduct primary research.